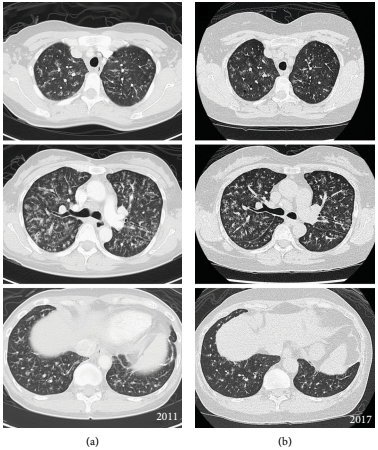

来源:医博士 | 2021-09-06 作者:李胜佳
淋巴细胞性间质性肺炎(LIP)是一种罕见的疾病。既往有研究表明,14年来收集的1167例间质性肺病(ILD)患者的肺活检中,只有15例发现LIP。LIP既被认为是一种疾病(罕见的特发性间质性肺炎),也被认为是一种对各种外界刺激或全身性疾病的非肿瘤性、炎症性肺部反应。LIP常见于结缔组织病(CTD),尤其是干燥综合征(SS)。对SS肺部受累的系统回顾报告,146例组织病理学诊断中,最常见的是非特异性间质性肺炎(45%),其次是毛细支气管炎(25%),常见间质性肺炎(16%)和LIP(15%)。
本病案报告一例无症状淋巴细胞性间质性肺炎伴HRCT广泛改变,6年后发展出SS的特征。
病例介绍
十年前,一位53岁的女性在进行选择性子宫切除术的术前评估时意外发现胸片异常。根据高分辨率计算机断层扫描(HRCT)(图1a)和肺活检报告,诊断为LIP,肺小叶间隔明显纤维化,弥漫性间质和细支气管周围淋巴浆细胞浸润,伴有散在的嗜酸性粒细胞。患者没有接受任何治疗,随后两年没有进行随访。
6年后,患者因8个月的咳嗽和呼吸困难病史就诊。6分钟步行距离为440 m,血氧饱和度为89%,肺功能试验(PFT)显示限制性,FEV1 53%,FVC 67%,DLCO 70%。重复HRCT显示弥漫性支气管血管周围增厚和磨玻璃样改变,双肺支气管血管束沿线有小囊肿(图1b)。
几个月后,当免疫学检查显示抗核抗体和抗Ro抗体呈阳性时,患者被转诊到风湿病科就诊。在呼吸系统症状出现三个月后开始出现眼睛干燥、口干和炎性关节痛。一个月前,皮肤科医生给她开了1mg/kg的泼尼松龙治疗皮肤血管炎,患者的呼吸系统症状有所改善。
图1. LIP的初次扫描(a)和6年后(b)的选定轴向CT图像
在风湿科就诊时,患者服用了20毫克的强的松龙,并报告皮肤血管炎复发。体格检查发现休息时室内空气中的氧饱和度为93%,肺部基底部有细裂纹,下肢有多处血管炎性病变。Schirmer's 试验呈阳性。异常血液检查包括贫血(血红蛋白10.8 g/dL)、血小板增多(血小板494×109/L)、血沉升高(86 mm/h)和高丙种球蛋白血症(球蛋白63 g/L)。患者还患有肺动脉高压(pH),平均肺动脉压为26 mmHg,毛细血管前楔压为9 mmHg。
LIP继发于原发性SS。泼尼松龙剂量增加到0.75mg/kg,硫唑嘌呤2mg/kg开始作为类固醇保留剂。在接下来的18个月内,患者因呼吸系统症状恶化而住院3次。因ILD加重(大剂量泼尼松龙)和呼吸道感染(静脉注射抗生素)接受治疗。在最后一次发作期间,患者还出现皮肤血管炎复发。此时,她同意使用泼尼松龙,但拒绝使用类固醇替代剂。令人惊讶的是,在过去的10个月里,患者病情保持稳定,服用了2.5毫克的强的松龙。患者对现状感到满意,并进行四个月的定期临床随访,没有住院。
讨论
通过本病案可得出一些重要的经验。首先,LIP是一种罕见的疾病,应寻找次要原因。在某些患者中,肺部受累先于CTD的其他全身症状,使得在诊断时无法区分特发性ILD和CTD-ILD。因此,提倡多学科团队的参与以确保对ILD的最佳管理。其次,尽管HRCT有广泛改变,本病案中的病人仍然无症状6年。虽然CT是检测肺部异常最敏感的方法,但影像学异常与肺功能检查和呼吸系统症状无关。SS的呼吸表现是多发性的,严重程度不同。肺受累的严重程度根据PFT结果和HRCT证实的ILD患者的功能分级进行分级。最后,并非SS的所有肺部表现都需要治疗,尤其是那些病情稳定的人。
尽管尚无针对肺部受累的SS的最终标准治疗方法,但如果存在进行性胸部症状,呼吸功能受损或明显的胸部异常或HRCT,则应使用诸如皮质类固醇和/或免疫抑制药物的免疫疗法。
医博士编译自:Baharuddin H, Hanafiah M, Aflah SSS, et al. Asymptomatic Lymphocytic Interstitial Pneumonia with Extensive HRCT Changes Preceding Sjogren's Syndrome. Case Reports in Pulmonology. 2021; 2021:6693031. doi:10.1155/2021/6693031.
声明: 所有注明“来源:医博士”的文字、图片和音视频资料,版权均属于医博士所有,转载须注明“来源:医博士”;所有转载文章系出于传递更多信息之目的,且明确注明来源和作者,不希望被转载的媒体或个人可与我们联系,我们将立即进行删除处理。